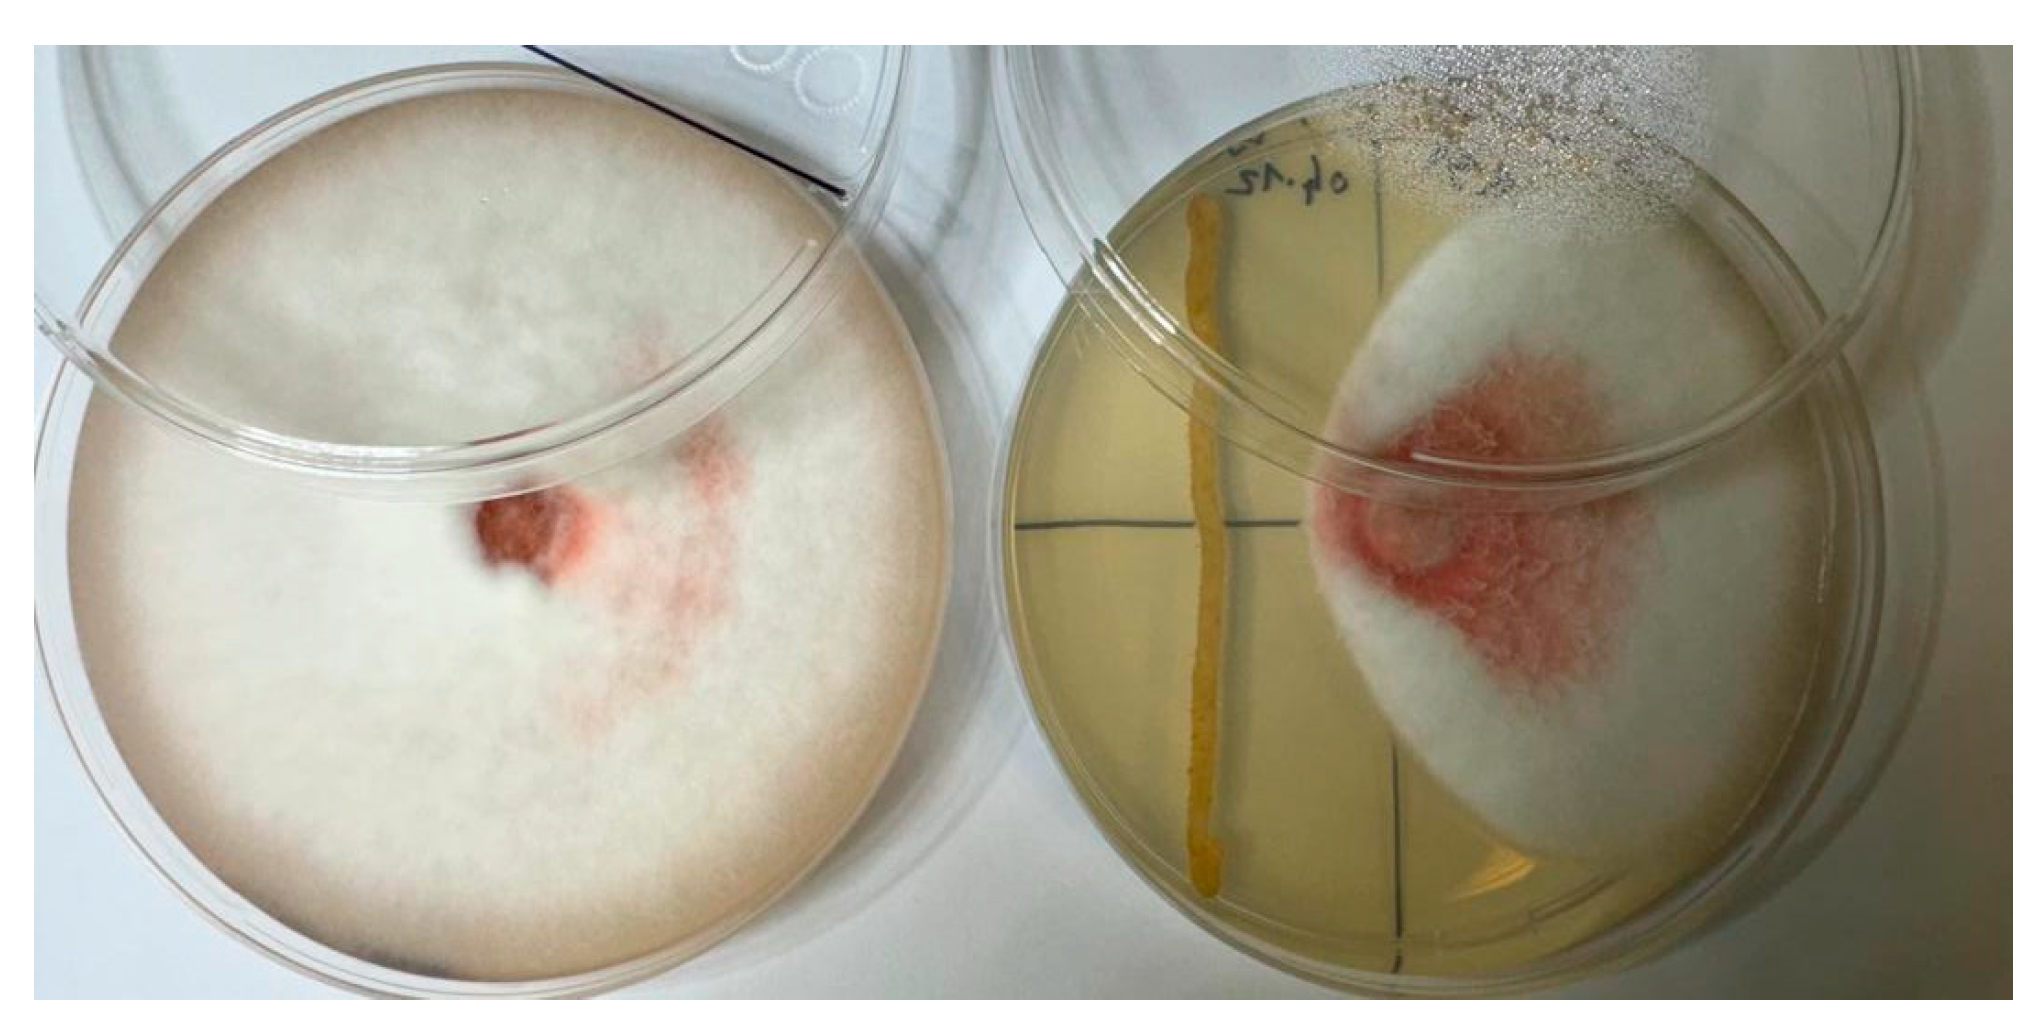
Plants 13 01684 g003

Exploring Endophytic Bacteria from Artemisia spp. and Beneficial Traits on Pea Plants
Abstract
:1. Introduction
2. Results
2.1. Isolation Endophytic Bacteria from Artemisia spp.
2.2. Molecular Identification of Endophytic Bacteria
2.3. Inhibitory Effect of Endophytic Bacteria on the Growth of Fusarium c.f. oxysporum
2.4. Phosphate Solubilization Index
2.5. Biochemical Properties and Effect of the Endophytic Bacteria on Pea Plant Growth
3. Discussion
3.1. Identification of Isolated Endophytic Bacteria
3.2. Antifungal Activity of Endophytic Bacteria
3.3. Plant Growth-Promoting Characteristics
4. Materials and Methods
4.1. Plant Sample Collection
4.2. Isolation Endophytic Bacteria
4.3. Molecular Identification of Isolated Endophytic Bacteria by 16srDNA
4.3.1. DNA Extraction from Bacteria Strains
4.3.2. Taxonomic Identification
4.4. Pathogenic Fungi Isolation
4.5. Growth Inhibition Effect of Endophytic Bacteria on Pea Root Rot Pathogen
4.6. Evaluation of Isolates for Their Plant Growth Promotion Potential
4.6.1. Indole Production Test
4.6.2. Phosphate Solubilization Activity of Endophytic Bacteria
4.6.3. Nitrogen Fixation Activity of Endophytic Bacteria
4.6.4. Impact of Endophytic Bacteria on Pea Seed Germination
Seed Inoculation with Endophytic Bacteria
Determination of Seed Germination and Plant Growth
4.7. Statistical Analysis
5. Conclusions
Author Contributions
Funding
Data Availability Statement
Conflicts of Interest
References
- Bódalo, A.; Borrego, R.; Garrido, C.; Bolivar-Anillo, H.J.; Cantoral, J.M.; Vela-Delgado, M.D.; González-Rodríguez, V.E.; Carbú, M. In Vitro Studies of Endophytic Bacteria Isolated from Ginger (Zingiber officinale) as Potential Plant-Growth-Promoting and Biocontrol Agents against Botrytis cinerea and Colletotrichum acutatum. Plants 2023, 12, 4032. [Google Scholar] [CrossRef] [PubMed]
- Morales-Cedeño, L.R.; Orozco-Mosqueda, M.d.C.; Loeza-Lara, P.D.; Parra-Cota, F.I.; de los Santos-Villalobos, S.; Santoyo, G. Plant Growth-Promoting Bacterial Endophytes as Biocontrol Agents of Pre- and Post-Harvest Diseases: Fundamentals, Methods of Application and Future Perspectives. Microbiol. Res. 2021, 242, 126612. [Google Scholar] [CrossRef] [PubMed]
- Yang, L.-L.; Jiang, Z.; Li, Y.; Wang, E.-T.; Zhi, X.-Y. Plasmids Related to the Symbiotic Nitrogen Fixation Are Not Only Cooperated Functionally but also May Have Evolved over a Time Span in Family Rhizobiaceae. Genome Biol. Evol. 2020, 12, 2002–2014. [Google Scholar] [CrossRef]
- Fan, D.; Smith, D.L. Characterization of Selected Plant Growth-Promoting Rhizobacteria and Their Non-Host Growth Promotion Effects. Microbiol. Spectr. 2021, 9, e0027921. [Google Scholar] [CrossRef] [PubMed]
- Duca, D.; Lorv, J.; Patten, C.L.; Rose, D.; Glick, B.R. Indole-3-Acetic Acid in Plant–Microbe Interactions. Antonie Van. Leeuwenhoek 2014, 106, 85–125. [Google Scholar] [CrossRef] [PubMed]
- Prudent, M.; Salon, C.; Souleimanov, A.; Emery, R.J.N.; Smith, D.L. Soybean Is Less Impacted by Water Stress Using Bradyrhizobium japonicum and Thuricin-17 from Bacillus thuringiensis. Agron. Sustain. Dev. 2015, 35, 749–757. [Google Scholar] [CrossRef]
- Pham, V.H.T.; Kim, J.; Chang, S.; Chung, W. Bacterial Biosorbents, an Efficient Heavy Metals Green Clean-Up Strategy: Prospects, Challenges, and Opportunities. Microorganisms 2022, 10, 610. [Google Scholar] [CrossRef] [PubMed]
- Ho, Y.-N.; Mathew, D.C.; Hsiao, S.-C.; Shih, C.-H.; Chien, M.-F.; Chiang, H.-M.; Huang, C.-C. Selection and Application of Endophytic Bacterium Achromobacter xylosoxidans Strain F3B for Improving Phytoremediation of Phenolic Pollutants. J. Hazard. Mater. 2012, 219–220, 43–49. [Google Scholar] [CrossRef] [PubMed]
- Sakai, M.; Hosoda, A.; Ogura, K.; Ikenaga, M. The Growth of Steroidobacter agariperforans sp. Nov., a Novel Agar-Degrading Bacterium Isolated from Soil, Is Enhanced by the Diffusible Metabolites Produced by Bacteria Belonging to Rhizobiales. Microbes Environ. 2014, 29, 89–95. [Google Scholar] [CrossRef]
- Zhang, X.; Chen, L.; Liu, X.; Wang, C.; Chen, X.; Xu, G.; Deng, K. Synergic Degradation of Diesel by Scirpus triqueter and Its Endophytic Bacteria. Environ. Sci. Pollut. Res. 2014, 21, 8198–8205. [Google Scholar] [CrossRef]
- Hadian, S.; Supronienė, S. The Potential of Artemisia spp. Plant Extracts and Endophytic Bacteria to Increase Plant Productivity: A Review. Zemdirb. Agric. 2023, 110, 87–94. [Google Scholar] [CrossRef]
- Awasthi, A.; Bharti, N.; Nair, P.; Singh, R.; Shukla, A.K.; Gupta, M.M.; Darokar, M.P.; Kalra, A. Synergistic Effect of Glomus mosseae and Nitrogen Fixing Bacillus subtilis Strain Daz26 on Artemisinin Content in Artemisia annua L. Appl. Soil Ecol. 2011, 49, 125–130. [Google Scholar] [CrossRef]
- Ebu, S.M.; Adem, M.A.; Dekebo, A.; Olani, A. Isolation and Identification of Endophytic Bacterial Isolates from the Leaves, Roots, and Stems Parts of Artemisia annua, Moringa oleifera, and Ocimum lamiifolium Plants. Curr. Microbiol. 2023, 80, 405. [Google Scholar] [CrossRef] [PubMed]
- Gordon, T.R. Fusarium oxysporum and the Fusarium Wilt Syndrome. Annu. Rev. Phytopathol. 2017, 55, 23–39. [Google Scholar] [CrossRef] [PubMed]
- Edel-Hermann, V.; Lecomte, C. Current Status of Fusarium oxysporum Formae Speciales and Races. Phytopathology 2019, 109, 512–530. [Google Scholar] [CrossRef] [PubMed]
- Nazir, N.; Badri, Z.A.; Bhat, N.A.; Bhat, F.A.; Sultan, P.; Bhat, T.A.; Rather, M.A.; Sakina, A. Effect of the Combination of Biological, Chemical Control and Agronomic Technique in Integrated Management Pea Root Rot and Its Productivity. Sci. Rep. 2022, 12, 11348. [Google Scholar] [CrossRef] [PubMed]
- El-Saadony, M.T.; Saad, A.M.; Najjar, A.A.; Alzahrani, S.O.; Alkhatib, F.M.; Shafi, M.E.; Selem, E.; Desoky, E.-S.M.; Fouda, S.E.E.; El-Tahan, A.M.; et al. The Use of Biological Selenium Nanoparticles to Suppress Triticum aestivum L. Crown and Root Rot Diseases Induced by Fusarium Species and Improve Yield under Drought and Heat Stress. Saudi J. Biol. Sci. 2021, 28, 4461–4471. [Google Scholar] [CrossRef]
- Sriwati, R.; Maulidia, V.; Intan, N.; Oktarina, H.; Syamsuddin; Khairan, K.; Skala, L.; Mahmud, T. Endophytic Bacteria as Biological Agents to Control Fusarium Wilt Disease and Promote Tomato Plant Growth. Physiol. Mol. Plant Pathol. 2023, 125, 101994. [Google Scholar] [CrossRef]
- Maulidia, V.; Sriwati, R.; Soesanto, L.; Syamsuddin; Hamaguchi, T.; Hasegawa, K. Endophytic Bacteria Isolated from Higher Plant in Aceh, Indonesia, and Their Chemical Compounds Activity against Fusarium oxysporum f. sp. lycopersici. Egypt. J. Biol. Pest. Control 2021, 31, 31. [Google Scholar] [CrossRef]
- Ghimire, K.; Peta, V.; Bücking, H.; Caffe, M. Effect of Non-Native Endophytic Bacteria on Oat (Avena sativa L.) Growth. Int. J. Plant Biol. 2023, 14, 827–844. [Google Scholar] [CrossRef]
- Yanni, Y.G.; Dazzo, F.B.; Zidan, M.I. Beneficial Endophytic Rhizobia as Biofertilizer Inoculants for Rice and the Spatial Ecology of This Bacteria–Plant Association. In Bacteria in Agrobiology: Crop Ecosystems; Springer: Berlin/Heidelberg, Germany, 2011; pp. 265–294. [Google Scholar] [CrossRef]
- Wu, W.; Chen, W.; Liu, S.; Wu, J.; Zhu, Y.; Qin, L.; Zhu, B. Beneficial Relationships Between Endophytic Bacteria and Medicinal Plants. Front. Plant Sci. 2021, 12, 646146. [Google Scholar] [CrossRef] [PubMed]
- Husseiny, S.; Dishisha, T.; Soliman, H.A.; Adeleke, R.; Raslan, M. Characterization of Growth Promoting Bacterial Endophytes Isolated from Artemisia annua L. S. Afr. J. Bot. 2021, 143, 238–247. [Google Scholar] [CrossRef]
- Ashitha, A.; Midhun, S.J.; Sunil, M.A.; Nithin, T.U.; Radhakrishnan, E.K.; Mathew, J. Bacterial Endophytes from Artemisia nilagirica (Clarke) Pamp., with Antibacterial Efficacy against Human Pathogens. Microb. Pathog. 2019, 135, 103624. [Google Scholar] [CrossRef] [PubMed]
- Du, H.; Li, C. Study on the Mechanism of Peanut Resistance to Fusarium oxysporum Infection Induced by Bacillus thuringiensis TG5. Front. Microbiol. 2024, 14, 1251660. [Google Scholar] [CrossRef] [PubMed]
- Shin, J.-H.; Lee, H.-K.; Lee, S.-C.; Han, Y.-K. Biological Control of Fusarium Oxysporum, the Causal Agent of Fusarium Basal Rot in Onion by Bacillus spp. Plant Pathol. J. 2023, 39, 600–613. [Google Scholar] [CrossRef] [PubMed]
- Pazarlar, S.; Madriz-Ordeñana, K.; Thordal-Christensen, H. Bacillus cereus EC9 Protects Tomato against Fusarium Wilt through JA/ET-Activated Immunity. Front. Plant Sci. 2022, 13, 1090947. [Google Scholar] [CrossRef] [PubMed]
- Abdelkhalek, A.; Behiry, S.I.; Al-Askar, A.A. Bacillus velezensis PEA1 Inhibits Fusarium oxysporum Growth and Induces Systemic Resistance to Cucumber Mosaic Virus. Agronomy 2020, 10, 1312. [Google Scholar] [CrossRef]
- Cruz Martín, M.; Leyva, L.; Acosta Suárez, M.; Pichardo, T.; Bermúdez Caraballoso, I.; Alvarado Capó, Y. Antifungal Activity of Bacillus amyloliquefaciens against Fusarium oxysporum f. sp. Cubense Race 1. Agron. Mesoam. 2021, 32, 466–478. [Google Scholar] [CrossRef]
- Meyer, S.L.F.; Everts, K.L.; Gardener, B.M.; Masler, E.P.; Abdelnabby, H.M.E.; Skantar, A.M. Assessment of DAPG-Producing Pseudomonas fluorescens for Management of Meloidogyne incognita and Fusarium oxysporum on Watermelon. J. Nematol. 2016, 48, 43–53. [Google Scholar] [CrossRef]
- Delfim, J.; Dijoo, Z.K. Bacillus thuringiensis as a Biofertilizer and Plant Growth Promoter. In Microbiota and Biofertilizers; Springer International Publishing: Cham, Switzerland, 2021; Volume 2, pp. 251–265. [Google Scholar] [CrossRef]
- Berza, B.; Sekar, J.; Vaiyapuri, P.; Pagano, M.C.; Assefa, F. Evaluation of Inorganic Phosphate Solubilizing Efficiency and Multiple Plant Growth Promoting Properties of Endophytic Bacteria Isolated from Root Nodules Erythrina brucei. BMC Microbiol. 2022, 22, 276. [Google Scholar] [CrossRef]
- de Almeida, J.R.; Bonatelli, M.L.; Batista, B.D.; Teixeira-Silva, N.S.; Mondin, M.; dos Santos, R.C.; Bento, J.M.S.; de Almeida Hayashibara, C.A.; Azevedo, J.L.; Quecine, M.C. Bacillus thuringiensis RZ2MS9, a Tropical Plant Growth-promoting Rhizobacterium, Colonizes Maize Endophytically and Alters the Plant’s Production of Volatile Organic Compounds during Co-inoculation with Azospirillum brasilense Ab-V5. Environ. Microbiol. Rep. 2021, 13, 812–821. [Google Scholar] [CrossRef] [PubMed]
- Widnyana, I.K.; Javandira, C. Activities Pseudomonas spp. and Bacillus sp. to Stimulate Germination and Seedling Growth of Tomato Plants. Agric. Agric. Sci. Procedia 2016, 9, 419–423. [Google Scholar] [CrossRef]
- Ma, Y.; Rajkumar, M.; Luo, Y.; Freitas, H. Inoculation of Endophytic Bacteria on Host and Non-Host Plants—Effects on Plant Growth and Ni Uptake. J. Hazard. Mater. 2011, 195, 230–237. [Google Scholar] [CrossRef] [PubMed]
- Zhao, C.; Onyino, J.; Gao, X. Current Advances in the Functional Diversity and Mechanisms Underlying Endophyte–Plant Interactions. Microorganisms 2024, 12, 779. [Google Scholar] [CrossRef] [PubMed]
- Duque, L.O.; Villordon, A. Root Branching and Nutrient Efficiency: Status and Way Forward in Root and Tuber Crops. Front. Plant Sci. 2019, 10, 237. [Google Scholar] [CrossRef] [PubMed]
- Kuhl-Nagel, T.; Rodriguez, P.A.; Gantner, I.; Chowdhury, S.P.; Schwehn, P.; Rosenkranz, M.; Weber, B.; Schnitzler, J.-P.; Kublik, S.; Schloter, M.; et al. Novel Pseudomonas sp. SCA7 Promotes Plant Growth in Two Plant Families and Induces Systemic Resistance in Arabidopsis thaliana. Front. Microbiol. 2022, 13, 923515. [Google Scholar] [CrossRef] [PubMed]
- LMU-Munich. Available online: https://2012.igem.org/Team:LMU-Munich (accessed on 10 July 2023).
- Marchesi, J.R.; Sato, T.; Weightman, A.J.; Martin, T.A.; Fry, J.C.; Hiom, S.J.; Wade, W.G. Design and Evaluation of Useful Bacterium-Specific PCR Primers That Amplify Genes Coding for Bacterial 16S rRNA. Appl. Environ. Microbiol. 1998, 64. [Google Scholar] [CrossRef]
- NCBI. Available online: https://blast.ncbi.nlm.nih.gov/Blast.cgi (accessed on 5 November 2023).
- Thompson, J.D.; Higgins, D.G.; Gibson, T.J. CLUSTAL W: Improving the Sensitivity of Progressive Multiple Sequence Alignment through Sequence Weighting, Position-Specific Gap Penalties and Weight Matrix Choice. Nucleic Acids Res. 1994, 22, 4673–4680. [Google Scholar] [CrossRef]
- Kumar, S.; Stecher, G.; Li, M.; Knyaz, C.; Tamura, K. MEGA X: Molecular Evolutionary Genetics Analysis across Computing Platforms. Mol. Biol. Evol. 2018, 35, 1547–1549. [Google Scholar] [CrossRef]
- Mitchell, J.I.; Zuccaro, A. Sequences, the Environment and Fungi. Mycologist 2006, 20, 62–74. [Google Scholar] [CrossRef]
- Sakoda, T.; Komuta, K.; Fujiwara, Y. Tokyo Sub-Station, Yokohama Plant Protection Station A Rapid and Simple Method for Inoculation with Fusarium oxysporum f. sp. Pisi by Using Hydroponic Culture. Res. Bull. Plant Prot. Jpn. 2018, 54, 77–82. Available online: https://www.maff.go.jp/pps/j/guidance/r_bulletin/pdf/rb054_006.pdf (accessed on 5 November 2023).
- Bhagya, M. Isolation and Characterization of Endophytic Bacteria from Nodule, Root and Seeds of Greengram (Vigna radiata L.). Int. J. Pure Appl. Biosci. 2019, 7, 319–328. [Google Scholar] [CrossRef]
- Pikovskaya, R.I. Mobilization of Phosphorus in Soil in Connection with Vital Activity of Some Microbial Species. Mikrobiologiya 1948, 17, 362–370. [Google Scholar]
- Gupta, R.; Singal, R.; Shankar, A.; Kuhad, R.C.; Saxena, R.K. A Modified Plate Assay for Screening Phosphate Solubilizing Microorganisms. J. Gen. Appl. Microbiol. 1994, 40, 255–260. [Google Scholar] [CrossRef]
- Wendimu, A.; Yoseph, T.; Ayalew, T. Ditching Phosphatic Fertilizers for Phosphate-Solubilizing Biofertilizers: A Step towards Sustainable Agriculture and Environmental Health. Sustainability 2023, 15, 1713. [Google Scholar] [CrossRef]
- Rfaki, A.; Nassiri, L.; Ibijbijen, J. Isolation and Characterization of Phosphate solubilizing Bacteria from the Rhizosphere of Faba Bean (Vicia faba L.) in Meknes Region, Morocco. Br. Microbiol. Res. J. 2015, 6, 247–254. [Google Scholar] [CrossRef]
- Ashby, S.F. Some Observations on the Assimilation of Atmospheric Nitrogen by a Free Living Soil Organism.—Azotobacter Chroococcum of Beijerinck. J. Agric. Sci. 1907, 2, 35–51. [Google Scholar] [CrossRef]
- Li, J.H.; Wang, E.T.; Chen, W.F.; Chen, W.X. Genetic Diversity and Potential for Promotion of Plant Growth Detected in Nodule Endophytic Bacteria of Soybean Grown in Heilongjiang Province of China. Soil. Biol. Biochem. 2008, 40, 238–246. [Google Scholar] [CrossRef]
- Baran, A.; Tarnawski, M. Phytotoxkit/Phytotestkit and Microtox® as Tools for Toxicity Assessment of Sediments. Ecotoxicol. Environ. Saf. 2013, 98, 19–27. [Google Scholar] [CrossRef]

| Isolate | Plant Species, Parts | Related Species | Similarity | Growth Inhibition | PSI | Indole Production Test | Nitrogen Fixation Test |
|---|---|---|---|---|---|---|---|
| AR11 | A. absinthium, root | Bacillus thuringiensis IAM12077 | 100% | 90.83% | 2.93 | + | + |
| AR32 | A. absinthium, root | Bacillus cereus ATCC14579 | 99.57% | 83.8% | 2.7 | − | + |
| AR35 | A. absinthium, root | Bacillus velezensis FZB42 | 100% | 80.8% | 2.33 | − | + |
| VR24 | A. vulgaris, root | Bacillus thuringiensis IAM12077 | 99.91% | 88% | - | − | + |
| VL13 | A. vulgaris, leaf | Bacillus cereus ATCC14579 | 99.98% | 56.36% | 2.5 | − | + |
| VS32 | A. vulgaris, stem | Bacillus cereus ATCC14579 | 99.91 | 54.43% | 2.3 | − | + |
| CR25 | A. campestris, root | Pseudomonas fluorescens IAM 12022 | 100% | 75.86% | 2.1 | + | + |
| DR31 | A. dubia, root | Bacillus amyloliquefaciens NBRC15535 | 100% | 60% | 2.6 | − | + |
Disclaimer/Publisher’s Note: The statements, opinions and data contained in all publications are solely those of the individual author(s) and contributor(s) and not of MDPI and/or the editor(s). MDPI and/or the editor(s) disclaim responsibility for any injury to people or property resulting from any ideas, methods, instructions or products referred to in the content. |
© 2024 by the authors. Licensee MDPI, Basel, Switzerland. This article is an open access article distributed under the terms and conditions of the Creative Commons Attribution (CC BY) license (https://creativecommons.org/licenses/by/4.0/).
Share and Cite
Hadian, S.; Smith, D.L.; Kopriva, S.; Norkevičienė, E.; Supronienė, S. Exploring Endophytic Bacteria from Artemisia spp. and Beneficial Traits on Pea Plants. Plants 2024, 13, 1684. https://doi.org/10.3390/plants13121684
Hadian S, Smith DL, Kopriva S, Norkevičienė E, Supronienė S. Exploring Endophytic Bacteria from Artemisia spp. and Beneficial Traits on Pea Plants. Plants. 2024; 13(12):1684. https://doi.org/10.3390/plants13121684
Chicago/Turabian StyleHadian, Shervin, Donald L. Smith, Stanislav Kopriva, Eglė Norkevičienė, and Skaidrė Supronienė. 2024. "Exploring Endophytic Bacteria from Artemisia spp. and Beneficial Traits on Pea Plants" Plants 13, no. 12: 1684. https://doi.org/10.3390/plants13121684






